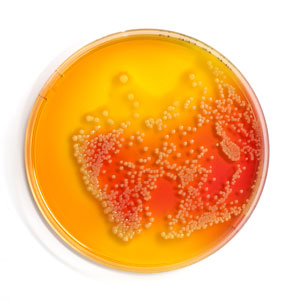

Das es in wassergemischten Kühlschmierstoffen gelegentlich zu Bakterienbefall kommen kann, haben nahezu alle Metaller bereits selbst erfahren. In diesen Fällen wird oft empfohlen, mit Bioziden zu arbeiten. Gelegentlich ist auch der Austausch des KSS erforderlich. Um zu verstehen wie man Bakterienbefall präventiv entgegenwirken kann, muss man wissen, wie Bakterien in Kühlschmierstoffen leben und wie sie in das Fluid gelangen. Bakterien können deshalb im Kühlschmierstoff leben, weil er alles enthält was sie brauchen: Nährstoffe, Sauerstoff, Mineralien und das Lebenselixier Wasser. Um Bakterienbefall zu verhindern, besitzen moderne Kühlschmierstoffe konservierende Stoffe. Diese bieten im Regelfall einen sicheren Schutz vor Verkeimung, solange die Sollkonzentrationen eingehalten und Bakterien nicht in großer Zahl dem System zugeführt werden.
Was richten Bakterien und Pilze im Kühlschmierstoff an?
Die Mikroorganismen ernähren sich von den einzelnen Bestandteilen des KSS, vermehren sich und hinterlassen Stoffwechselprodukte. Moderne wassergemischte Kühlschmierstoffe sind komplexe Mischungen verschiedener Komponenten. Diese erfüllen wichtige Aufgaben. So sorgen schmierwirksame Bestandteile für die Verringerung von Reibung zwischen Werkstück, Werkzeug und Span. Emulgatoren sind die Voraussetzung für eine stabile Emulsion und bestimmte Dispersität. Inhibitoren schützen vor Korrosion und Oberflächenangriff. Entschäumer unterdrücken die Schaumbildung im System, und Konservierungsmittel verhindern die Vermehrung von Keimen. Fehlen einzelne Komponenten in diesem komplexen System, so ist der KSS in seiner Funktionalität gestört.
Zusätzlich zum Abbau der einzelnen KSS-Inhaltsstoffe reichern sich die Stoffwechselprodukte im System an. So entsteht z.B. aus schwefelhaltigen Molekülen der stinkende Schwefelwasserstoff und aus Ölen wird Kohlendioxid und Wasser. Bei der Verstoffwechselung von Stickstoffverbindungen entsteht unter anderem Nitrit; daher kann ein Anstieg des Nitritgehaltes (Messung nach TRGS 611) ein Indikator für Keimwachstum im KSS sein.
Auch die Vermehrung der Mikroorganismen selbst führt zu Problemen. So bilden einige Bakterien Biofilme aus, welche einzelne Leitungen im System verstopfen. Auch Pilzfäden können sich lösen und Rohrleitungen zusetzen. Verschiedene Bakterien produziere Endotoxine, die Atembeschwerden auslösen können.
Wie gelangen die Bakterien in den Kühlschmierstoff?
Für Keime führen “viele Wege nach Kühlschmierstoff“. Wir leben in keiner sterilen Welt. Mikroorganismen umgeben uns überall. So werden Bakterien z.B. durch das Ansetzwasser, welches zum Mischen des Kühlschmierstoffs verwendet wird, in das System eingeführt. Auch durch Bodenschmutz und die Umgebungsluft können Mikroorganismen in den Kühlschmierstoff gelangen. Einträge durch das Werkstück selbst sind ebenfalls nicht selten. Eine weitere nicht zu unterschätzende Einfallsquelle stellt der Mensch selbst dar. Hier erfolgt die Kontamination durch die Hände, Schweiß und Speichel.
Vorbeugen ist besser als behandeln!
Als Kühlschmierstoffanwender sollte man die Einträge von Mikroorganismen in den Kühlschmierstoff auf ein Minimum reduzieren. Des weiteren sollten Sie Ihren Kühlschmierstoff pflegen und stets die Mindestkonzentration einhalten. Vermeiden Sie große Volumenschwankungen im KSS-Tank und füllen Sie lieber häufiger auf. Große Volumenschwankungen bedeuten gleichzeitig große Schwankungen in der KSS-Konzentration, da der Großteil des Volumenverlustes durch verdunstendes Wasser verursacht wird. Dies macht zum einen die temporäre Unterkonzentration wahrscheinlicher. Zum anderen bedeuten geringere Schwankungen in der Konzentration auch einen geringeren KSS-Verbrauch und lohnen sich monetär. Hier die Top Ursachen für mikrobiologisches Wachstum im KSS:
Nur Wasser auffüllen
Auch wenn die Konzentration der Emulsion zu hoch ist, sollten Sie den KSS-Tank nicht mit reinem Wasser auffüllen. Füllen Sie den Tank lieber mit einer niedriger dosierten Emulsion/Lösung auf. Hierdurch verringern sie das Ausmagern einzelner Bestandteile Ihrer Metallbearbeitungsflüssigkeit.
Müll, Zigaretten und Essensreste
Leider immer noch zu beobachten. Müll, Essenreste und Zigaretten gehören nicht in den KSS! Sie kontaminieren ihn und bieten gleichzeitig Nährstoffe für Keime.
Verwendung von Brunnenwässern oder Regenwasser als Ansetzwasser für Kühlschmierstoffe
Brunnen- und Regenwässer eignen sich nicht als Ansetzwasser für KSS. Oft gelangt mit diesen Wässern eine große Anzahl Mikroorganismen in das System. Auch ist die wechselnde Qualität des Wassers (Härte, Chlorid, Sulfat, Nitrat etc.) eher ungeeignet für die Verwendung in Kühlschmierstoffen.
Wasser aus der Umkehrosmose/Wasseraufbereitung ist mikrobiologisch belastet
Eine Verkeimung in der Anlage und den Vorratsbehältern kommt in der Praxis nicht selten vor. Ist das Ansetzwasser bereits stark kontaminiert, so führen Sie die Keime kontinuierlich dem System zu, und es kann trotz Behandlung des KSS immer wieder zum “Umkippen” kommen. Prüfen Sie regelmäßig Ihr Osmose-Wasser auf Verkeimung und leiten im Bedarfsfall geeignete Maßnahmen ein.
Als Zuleitung zum Kühlschmierstoff wird ein (Garten-) Wasserschlauch verwendet
Das stehende Wasser in einem Gartenschlauch bietet Bakterien gute Voraussetzungen für Wachstum. Vor allem wenn der Innenschlauch durch Alterung bereits porös ist, bietet er hervorragende Anhaftbedingungen für Bakterien. Wir empfehlen bei Verwendung von Schläuchen eine regelmäßige Kontrolle. Leeren Sie den Schlauch bei längerem Nichtgebrauch und tauschen sie ihn regelmäßig aus.
Rückführung von Emulsion aus dem Spänebehälter
Verschleppung von Emulsion durch Anhaftung am Span ist nicht gänzlich zu verhindern. Durch bestimmte Anpassungen, z.B. Taktung des Späneförderers, lässt sich der Austrag minimieren. Es bleibt jedoch immer ein Teil der Emulsion anhaften, landet mit den Spänen im Kübel und sammelt sich am Boden. Es erscheint im ersten Moment logisch sich die Entsorgung dieser Emulsion zu ersparen, indem man sie dem KSS-Tank zurückführt. Doch stand die Emulsion in der Regel lange still, ist sie kontaminiert und sollte besser entsorgt werden.
Unterkonzentration des Kühlschmierstoffes
Die Kühlschmierstoffkonzentration sollte stets im Arbeitsbereich der Emulsion sein. Eine Unterdosierung bedeutet auch, dass weniger konservierende Stoffe im Falle einer Kontamination zur Verfügung stehen und mikrobiologisches Wachstum ermöglichen. Achten Sie bei der Messung der Konzentration darauf, dass das Refraktometer kalibriert ist und beachten Sie den Refraktometerfaktor Ihres Kühlschmierstoffes. Eine detailierte Anleitung finden Sie in der helcotec Kühlschmierstoff-Fibel.
UNSER TIPP
Mit dem kostengünstigen KSS-Nachfüllsystem helcool® Fill , brauchen Sie Ihre Maschinen nie wieder von Hand zu befüllen und stellen gleichzeitig die optimale KSS-Konzentration sicher. Wichtige Wirkstoffe in Ihrer Emulsion werden mehrmals täglich nachdosiert und stabilisieren Ihr System.
Damit bietet Ihnen helcool® Fill die Antwort auf die immer größer werdenden Herausforderungen einer kontinuierlichen 24/7-Produktion und erschließt Ihnen Potentiale in den Bereichen KOSTENREDUKTION, PROZESSSICHERHEIT, MITARBEITERSCHUTZ und VERFÜGBARKEIT.
Machen Sie sich keine Sorgen mehr über die korrekte Konzentration, die Qualität und den Füllstand ihrer Kühlschmierstoffe. Hier erfahren Sie mehr: helcool® Fill
Fremdöleintrag
Bei hohem Eintrag von Fremdölen, z.B. Hydrauliköl oder Bettbahnschmierung, setzt sich das Öl auf der Oberfläche der Emulsion ab. Ein Luftaustausch wird verhindert und das Wachstum anaerober Bakterien begünstigt. Durch den Einsatz von z.B. Skimmern und Abscheidern lässt sich das aufschwimmende Öl sehr gut entfernen.
Längere Stillstandzeiten
Kontaktieren Sie Ihren KSS-Lieferanten vor geplanten längeren Stillstandzeiten! Diese bieten beste Bedingungen für mikrobiologisches Wachstum. Ihr Lieferant kann die Zusammensetzung Ihres Kühlschmierstoffes genaustens analysieren und das Bioziddepot gezielt anpassen. Ziel ist es, den Kühlschmierstoff für den Stillstand zu rüsten und ein “Umkippen” zu verhindern.
Was tun, wenn sich Bakterien oder Pilze im KSS-System vermehren?
Bei Ihrer KSS-Überprüfung fällt Ihnen auf, dass der Nitrit-Wert gestiegen ist? Zusätzlich ist der pH-Wert abgefallen oder Ihr Kühlschmierstoff riecht anders bzw. hat sich im Aussehen verändert? Mit großer Wahrscheinlichkeit haben sich die Keime in Ihrem KSS vermehrt!
Jetzt sollten Sie handeln, denn wenn sich Mikroorganismen über längere Zeit ungehindert in Ihrem KSS vermehren, lässt sich dieser nur schwer wieder in einen gebrauchsfähigen Zustand bringen. Dann wird meist eine Reinigung mit Neubefüllung der Anlage notwendig.
Prüfen Sie die KSS-Konzentration und stellen Sie sicher, dass die vorgegebene Konzentration eingehalten wird. Bei größerem Abfall des pH-Wertes heben Sie den pH-Wert an, Ihr Kühlschmierstofflieferant empfiehlt Ihnen ein Produkt. Setzen Sie ein geeignetes Mittel zur Entkeimung ein, dieses erhalten Sie in der Regel von Ihrem KSS-Lieferanten. Achten Sie darauf, dass das Biozid gemäß der EU-“Verordnung über Biozidprodukte” der Produktart 13 (PT13/ Schutzmittel für Bearbeitungs- und Schneideflüssigkeiten) zugeordnet ist. Bitte verwenden Sie Biozidprodukte stets vorsichtig und beachten Sie die Etikett und Produktinformationen!
Falls Sie sich unsicher sind, welche Maßnahmen Sie ergreifen sollten und wie Sie mit Bioziden umgehen sollten, wenden Sie sich an uns. Wir helfen gerne weiter. Telefon 02166/144010 oder verwenden Sie das Kontaktformular auf unserer Homepage.
Welche Bakterien und Mikroorganismen befallen Kühlschmierstoffe?
Über 300 verschiedene Arten von Bakterien wurden bisher in Kühlschmierstoffen nachgewiesen. Einige sind häufig anzutreffen, andere wiederum sehr selten. Infektionen durch Mikroorganismen sind, in diesem Zusammenhang, selten zu finden. Immer noch selten, jedoch häufiger verursachen die Bestandteile der Mikroorganismen oder deren Stoffwechselabbauprodukte (Metaboliten) Beschwerden und gesundheitliche Probleme.
Hier die häufigsten ungebetenen Gäste im KSS:
Pseudomonas
In über 50% der Fälle gehören Bakterien, die in KSS gefunden werden, den Pseudomonas an. Die häufigsten Arten im KSS sind P. aeriginosa, P. putida, P. pseudoalcaligenes, P. oleovoranz und P. stutzeri. Die meisten Pseudomonas gehören zu den opportunistischen Erregern, und können somit Infektionen bei Menschen mit beeinträchtigter Immunität auslösen. Eine Infektion der Mitarbeiter in der Metallindustrie ist sehr unwahrscheinlich. Jedoch sind Pseudomonas in der Lage Endotoxine zu bilden. Diese Bakterien nennt man Gram-negative Bakterien. Ihre Membran befindet sich unterhalb einer schützenden Hülle. Wenn diese Membran zerstört wird, werden Endotoxine freigesetzt. Größere Mengen dieser Endotoxine können Atemwegsbeschwerden auszulösen.
Mykobakterien
In wassergemischten KSS finden sich auch häufig die Mykobakterien M. chelonae, M immunogenum und M. avium. Diese Mykobakterien gehören auch zu den opportunistischen Erregern. Somit ist eine Infektion mit diesen Erregern in der Metallbranche sehr unwahrscheinlich. Mykobakterien sind Gram-positiv und erzeugen keine Endotoxine.
Bacillus
Bacillus sind Gram-positive Bakterien und damit nicht in der Lage, Endotoxine zu produzieren. Die Arten B. subitilus und B. cereus sind hier die häufigsten Gäste im KSS. Bacillus Bakterien sind überwiegend nicht patogen und lösen keine Infektion aus.
Pilze
Schimmel und Hefen lassen sich oft in wassergemischten Kühlschmierstoffen nachweisen. Pilze werden unter anderem mit der Entstehung von Allergien und Asthma in Verbindung gebracht. Die häufigsten Vertreter dieser Gattung im KSS sind: Fusarium, Penecillium, Trichoderma, Exophiala, Aspergillus, Cladosporium und Cepalosporium.
Fazit
Die Kontamination des Kühlschmiestoff durch Mikroorganismen lässt sich gänzlich nicht vermeiden – unsere Welt ist keine steriele Welt -Durch geeignete Pflegemaßnahmen, regelmäßige Prüfungen und sachgemäßen Umgang können Sie jedoch das Risiko eines “umkippens” des Kühlschmiestoffes signifikant verringern. Sofern alle technischen Anforderungen erfüllt werden können Sie bei der Auswahl des Kühlschmierstoffes auf besonders stabile/weniger anfällige KSS zurückgreifen. Ein Beispiel für einen solchen Kühlschmiestoff ist das helcool Basic 443 EP, welches neben seiner Stabilität mit einem breiten Bearbeitungs- und Materialspektrum punktet.
Aquacid 500 S
Aquacid 500 S ist ein schnell wirkendes Biozid mit einem breiten Wirkungsspektrum gegen Bakterien, Hefen und Pilze.
- Wirkt nicht nur schnell durch die Kombination zweier Wirkstoffe, sondern verhindert auch langfristig die Neuverkeimung (Depotwirkung)
- Ist zum Schutz wasserführender Systeme wie Kühlschmierstoffemulsionen bis hin zu Klima und Kühlkreisläufen einsetzbar
- pH-stabil im Bereich von pH 2 – pH 9
- Wirksam gegen Pseudomonas aeruginosa
helcotec IQ-SR
Wassermischbarer, aminfreier Systemreiniger. Hervorragend geeignet zur Reinigung von Kühlschmierstoffanlagen.
- Hochkonzentriert und daher sehr sparsam in der Anwendung (Ca. 2% des Tankvolumens)
- Hat eine ausgesprochen gute Reinigungs- und Spülwirkung
- Entfernt zuverlässig Verunreinigungen
- aus Maschinenarbeitsräumen
- Versorgungsleitungen,
- Späneförderer
- Kühlschmierstofftanks.
- Die Standzeit der Emulsionen wird so deutlich verlängert
- In allen gängigen Kühlschmierstoffemulsionen einsetzbar
- Aminfrei, daher bessere Buntmetallverträglichkeit
Bandskimmer
Entfernt zuverlässig aufschwimmende Fremdöle
- Standzeitverlängerung durch das Entfernen von aufschwimmendem Fremdöl
- Einfache Befestigung mit Magnetfuß
- In 6 Stufen regelbar
- Universell über zwei Gelenke verstellbar
- Optional mit Zeitschaltuhr IP-44 lieferbar
Servicekoffer für Kühlschmierstoffe
Mit dem helcotec Servicekoffer für Kühlschmierstoffe haben Sie stehts alle notwendigen Messmittel für die Überprüfung gemäß TRGS 611 dabei. Ebenfalls beinhaltet der Servicekoffer eine bewährte KSS-Praxishilfe, die bei der Interpretation der Messwerte hilft und bei Bedarf geeignete Maßnahmen empfiehlt.
Inhalt
- Handrefraktometer 0-10°Brix
- Kombistäbchen pH/Nitrit
- Teststäbchen Kupfer
- Teststäbchen Gesamthärte
- 2 Pipetten
- helcotec KSS-Fibel
- KSS-Praxishilfe
Kühlschmierstoff-Fibel
Noch mehr praxisrelevante Infos zum Thema Kühlschmierstoffe finden Sie in der helcotec Kühlschmierstoff-Fibel. Erfahren Sie hier mehr zur Geschichte, den Aufgaben und den Inhaltsstoffen der Kühlschmierstoffe. Ebenfalls wird die Kühlschmierstoffpflege und -Überwachung detailliert und praxisnah behandelt. Auch der Bereich Problembehandelung und Störungsbeseitigung kommt nicht zu kurz.

helcool® Basic 443 EP
helcool® Basic 443 EP ist ein wassermischbarer EP-Kühlschmierstoff mit mittlerem Mineralöl-gehalt. helcool® Basic 443 EP ist universell einsetzbar für die Zerspanung verschiedenster Legierungen, wie z.B. Stahl, Grauguss und Aluminium.
Vorteile:
- Feindisperse Emulsion mit niedrigen Austragsverlusten
- Schaumarme Formulierung bei unterschiedlichen Wasserqualitäten
- Gute Hautverträglichkeit und milder Geruch sorgen für hohe Akzeptanz
- Hohe Langzeitstabilität bei optimalem Ablaufverhalten bieten hohe Prozesssicherheit
- Auch für Schleifbearbeitung geeignet